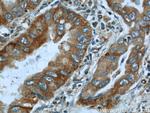
IMPDH2 Antibody in Immunohistochemistry (Paraffin) (IHC (P))

Search
Proteintech
IMPDH2 Polyclonal Antibody
{{$productOrderCtrl.translations['antibody.pdp.commerceCard.promotion.promotions']}}
{{$productOrderCtrl.translations['antibody.pdp.commerceCard.promotion.viewpromo']}}
{{$productOrderCtrl.translations['antibody.pdp.commerceCard.promotion.promocode']}}: {{promo.promoCode}} {{promo.promoTitle}} {{promo.promoDescription}}. {{$productOrderCtrl.translations['antibody.pdp.commerceCard.promotion.learnmore']}}
产品信息
12948-1-AP
种属反应
已发表种属
宿主/亚型
分类
类型
抗原
偶联物
形式
浓度
规格
纯化类型
保存液
内含物
保存条件
运输条件
产品详细信息
Immunogen sequence: MADYLISGG TSYVPDDGLT AQQLFNCGDG LTYNDFLILP GYIDFTADQV DLTSALTKKI TLKTPLVSSP MDTVTEAGMA IAMALTGGIG FIHHNCTPEF QANEVRKVKK YEQGFITDPV VLSPKDRVRD VFEAKARHGF CGIPITDTGR MGSRLVGIIS SRDIDFLKEE EHDCFLEEIM TKREDLVVAP AGITLKEANE ILQRSKKGKL PIVNEDDELV AIIARTDLKK NRDYPLASKD AKKQLLCGAA IGTHEDDKYR LDLLAQAGVD VVVLDSSQGN SIFQINMIKY IKDKYPNLQV IGGNVVTAAQ AKNLIDAGVD ALRVGMGSGS ICITQEVLAC GRPQATAVYK V (1-350 aa encoded by BC012840)
靶标信息
This gene encodes the rate-limiting enzyme in the de novo guanine nucleotide biosynthesis. It is thus involved in maintaining cellular guanine deoxy- and ribonucleotide pools needed for DNA and RNA synthesis. The encoded protein catalyzes the NAD-dependent oxidation of inosine-5'-monophosphate into xanthine-5'-monophosphate, which is then converted into guanosine-5'-monophosphate. This gene is up-regulated in some neoplasms, suggesting it may play a role in malignant transformation.
仅用于科研。不用于诊断过程。未经明确授权不得转售。
生物信息学
蛋白别名: epididymis secretory sperm binding protein; IMP (inosine 5'-monophosphate) dehydrogenase 2; IMP (inosine monophosphate) dehydrogenase 2; IMP dehydrogenase 2; IMP dehydrogenase 2 {ECO:0000255|HAMAP-Rule:MF_03156}; IMP dehydrogenase II; IMP dehydrogenase type II; IMP oxireductase 2; IMPD 2; IMPD 2 {ECO:0000255|HAMAP-Rule:MF_03156}; IMPDH 2; IMPDH 2 {ECO:0000255|HAMAP-Rule:MF_03156}; IMPDH II; IMPDH-II; inosine 5' phosphate dehydrogenase 2; inosine 5'-phosphate dehydrogenase 2; inosine 5-monophosphate dehydrogenase 2; inosine monophosphate dehydrogenase 2; inosine monophosphate dehydrogenase type II; inosine-5'-monophosphate dehydrogenase (EC 1.1.1.205); Inosine-5'-monophosphate dehydrogenase 2; inosine-5'-monophosphate dehydrogenase 2 {ECO:0000255|HAMAP-Rule:MF_03156}; Inosine-5'-monophosphate dehydrogenase type II; unnamed protein product
基因别名: IMPD; IMPD 2; IMPD2; IMPDH 2; IMPDH-II; IMPDH2
UniProt ID: (Human) P12268, (Rat) E9PU28, (Mouse) P24547
Entrez Gene ID: (Human) 3615, (Rat) 301005, (Mouse) 23918